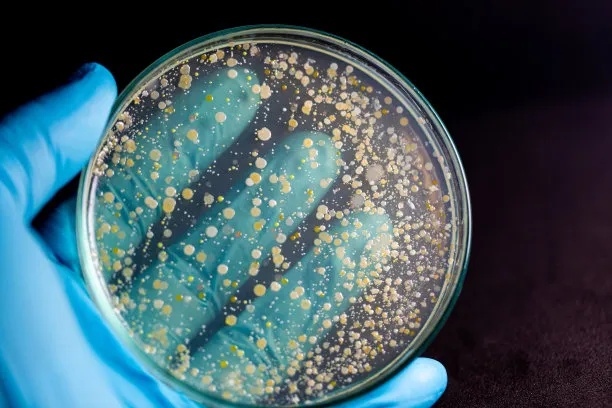

微生物菌种查询网:连接全球资源的科研基础设施
一、行业背景:微生物资源的战略基石作用
微生物作为生命科学领域最基础的研究对象之一,其在生物医药、环境治理与食品安全等关键领域的应用价值日益凸显。从疫苗研发到抗生素筛选,从污染物降解到食品致病菌检测,高质量的微生物菌种已成为现代科研不可或缺的核心要素。例如,在生物医药领域,特定标准菌种被广泛用于抗菌药物敏感性试验和无菌检查;在环境健康方向,具有特殊代谢能力的降解菌株为土壤修复与废水处理提供了可持续解决方案;而在食品安全监控中,质控菌种——用于实验室质量控制的标准微生物,是确保检测结果准确性的必要工具。
近年来,随着组学技术的发展,微生物资源的系统性积累正成为推动重大科研突破的关键支撑。吴清平院士团队构建的食品微生物安全基因组数据库,保藏食源性致病菌近4万株,显著提升了我国食品工业的微生物风险防控能力。华大生命科学研究院主导建立的全球海洋微生物组目录(GOMC),整合超过4.3万个基因组数据,从中挖掘出多个新型抗菌肽及高活性塑料降解酶,展示了深海微生物的巨大潜力。这些成果表明,微生物不仅是研究生命的窗口,更是驱动技术创新的重要资源库。在此背景下,如何高效获取并利用这些分散分布的生物材料,已成为科研实践中亟待解决的问题。

现代化微生物实验室内景:洁净台、培养箱与研究人员操作场景
二、科研需求:菌种获取面临的现实瓶颈
尽管微生物资源的重要性已被广泛认知,但科研人员在实际工作中仍面临诸多操作层面的挑战。传统菌种获取方式多依赖同行交流或直接向海外保藏机构申请,流程繁琐且周期漫长,通常需要数周至数月才能完成从查询到实物交付的全过程。信息不对称问题尤为突出:目标菌株可能分散于不同国家的多个保藏中心,研究人员需逐一访问各机构网站进行比对,缺乏统一入口导致检索效率低下。
此外,部分资源提供的元数据不完整,如缺少详细的培养条件、生理生化特性或基因组信息,直接影响实验设计的准确性与结果的可重复性。运输过程中的冷链管理不当也常导致菌种复苏失败,尤其对于厌氧菌或极端环境来源的菌株,活性保障难度更高。一些国际保藏机构虽提供标准化产品,但进口审批、清关手续复杂,进一步延长了等待时间。这些问题共同构成了当前科研活动中“找得到却拿不到”的困境。面对高通量筛选与快速迭代的研究节奏,传统的点对点获取模式已难以满足需求,亟需一个能够整合多方资源、优化服务流程的信息枢纽,以实现从“被动等待”到“主动响应”的转变。
三、全球资源格局与国际合作:权威保藏中心的数据透视
当前全球微生物资源分布呈现出高度专业化与区域集聚并存的格局。美国典型培养物保藏中心(American Type Culture Collection, ATCC)作为非营利性标准品资源机构,截至2025年保藏近29,000种生物材料,涵盖细菌、细胞系、病毒及重组分子等多种类型,其中菌株超15,000种,广泛应用于医学诊断与工业验证。德国微生物与细胞保藏中心(Leibniz Institute DSMZ-German Collection of Microorganisms and Cell Cultures)则以综合性著称,保藏生物材料超过70,000种,尤其擅长厌氧菌与极端环境微生物的长期保存,并提供详尽的技术文档支持。
荷兰真菌生物多样性中心(Centraalbureau voor Schimmelcultures, CBS)专注于真菌类群,累计保藏活体真菌菌株超10万株,覆盖约80%的已知真菌属,是全球最大的真菌资源库,馆藏包括酵母菌、霉菌、植物病原菌及模式标本等。日本微生物菌种保藏委员会(Japan Collection of Microorganisms, JCM)依托理化学研究所Riken生物资源中心,保藏超过20,000种微生物材料,包含32,000多株细菌、6,500多株真菌以及多种质粒与细胞系,在亚太地区具有较强影响力。据行业报告统计,截至2023年,全球国家级微生物菌种保藏中心已超过60个,总保藏量突破300万株,形成了覆盖多生态系统的实物资源网络。世界微生物数据中心(WDCM)已整合来自46个国家120个机构的40万株微生物数据,成为促进国际共享的重要平台。然而,这些机构独立运作的现状仍使得跨库检索成本较高,客观上制约了资源的高效流通。

恒温培养箱内部实景:摆放整齐的培养皿与三角瓶,体现标准化培养环境
四、平台功能与资源覆盖:微生物菌种查询网的核心整合能力
为应对上述挑战,由北京百欧博伟生物技术有限公司建设运营的微生物菌种查询网(www.biobw.org)应运而生,致力于打造连接国内外资源的信息枢纽。该平台通过系统集成ATCC、DSMZ、CBS、JCM等国际权威保藏机构的数据资源,实现了跨库检索与统一查询功能,显著降低了科研人员的信息搜寻成本。截至目前,平台收录国内外菌种超12万株,其中既包括常见模式菌株,也涵盖特殊功能菌种,基本覆盖生命科学研究的主要需求类型。
除菌种资源外,该平台还整合细胞资源逾1万株,适用于细胞生物学与免疫学相关研究;公开整理培养基配方5000余套,涵盖各类选择性、鉴别性及专用培养基,为实验复现提供参考依据;同时收录质粒载体400余枚,涉及常用克隆载体与表达系统,便于分子生物学操作。所有数据均定期更新,确保与源头机构保持同步。平台特别强化了对标准菌种与质控菌种的分类管理,用户可通过关键词快速定位金黄色葡萄球菌、大肠埃希氏菌、黑曲霉等常用参照菌株,满足实验室方法验证与合规检测的需求。这种多层次、结构化的资源整合模式,使该平台逐步发展为集信息查询、资源导航与服务对接于一体的综合性入口。
五、技术服务与应用支持:从信息平台到综合服务体系
在信息整合的基础上,微生物菌种查询网进一步延伸至技术服务层面,构建起贯穿资源获取与应用全过程的支持体系。平台背后依托专业实验室,配备Biolog微生物鉴定系统、超低温冰箱与生物安全柜等设备,可开展菌种鉴定、纯化与定量制备等常规实验服务。针对高频使用场景,提供4代定量菌悬液定制服务,浓度范围涵盖10E3至10E6 CFU/mL,适用于消毒效果验证与抑菌试验。
为便利国际资源引进,该平台代理法国梅里埃MBL、BIOBALL、赛默飞REMEL等多个国际知名品牌的标准质控产品,并建立稳定的进口通道,缩短货期的同时确保运输合规性与菌种活性。所有进口菌种均附带COA分析证书,支持多中心方法学验证需求。全程项目保障机制贯穿样本接收、处理、储存与配送环节,采用多重备份保藏技术(如冻干管、-80℃冷冻与液氮保存),最大限度降低丢失风险。目前,该平台的服务网络已覆盖北京大学、中国医学科学院、武汉大学口腔医院、南京农业大学等多家科研院所与医疗机构,反映出其在专业领域的广泛认可度。通过将信息查询与实体服务相结合,该平台为科研人员提供了高效获取微生物资源的新途径。
琼脂平板上多彩菌落形态特写:展示不同颜色与纹理的微生物生长结果
免责声明:此文内容为广告或转载宣传资讯,相关素材由广告主提供,与本网无关。仅供读者参考并请自行核实相关内容。


